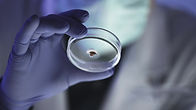

top of page

AT MLS, WE PRIDE OURSELVES TO BE THE PREMIER TESTING LABORATORY IN THE REGION
Our Laboratory
Marchwood Laboratory Services Pte Ltd provides a variety of environmental analytical testing services. We specialize in examining soil/sediment, water (raw, waste, drinking, catchment, recycled, saline, product), and air (indoor, stack, ambient).
Our testing facilities are staffed by skilled personnel and equipped with technologies at the forefront of innovation. This means that hazards are minimized, efficiency improved, quality and safety are uncompromised.
Our analytical techniques are grounded in well-established, internationally accepted practices such as those by the United States Environmental Protection Agency (USEPA) and the American Public Health Association (APHA).
bottom of page